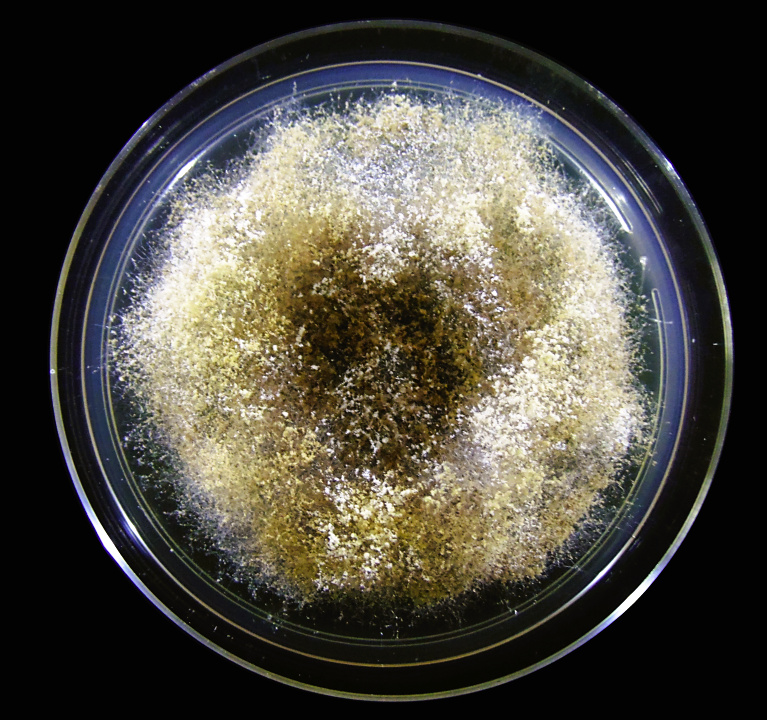
#Fungo ‘parasita’ teria surgido 18 milhões de anos antes de #formigas com as quais vive hoje. Achado é fruto da análise de 309 linhagens do gênero Escovopsis, coletadas em oito países das Américas. agencia.fapesp.br/55845

ComCiência
@revcomciencia
ComCiência (ISSN 1519-7654) é uma revista de jornalismo científico publicada desde 1999 pelo Laboratório de Estudos Avançados em Jornalismo @Labjor_Unicamp
ID: 921749494978502659
http://www.comciencia.br/ 21-10-2017 14:46:19
2,2K Tweet
4,4K Takipçi
101 Takip Edilen








Circulação de águas do #Atlântico pode enfraquecer de modo inédito até 2100 e impactar #chuva na #Amazônia. Publicado em Nature Communications por cientistas de Alemanha, Suíça e Brasil, estudo combinou dados de pesquisa de campo com projeções de modelos climáticos agencia.fapesp.br/55791